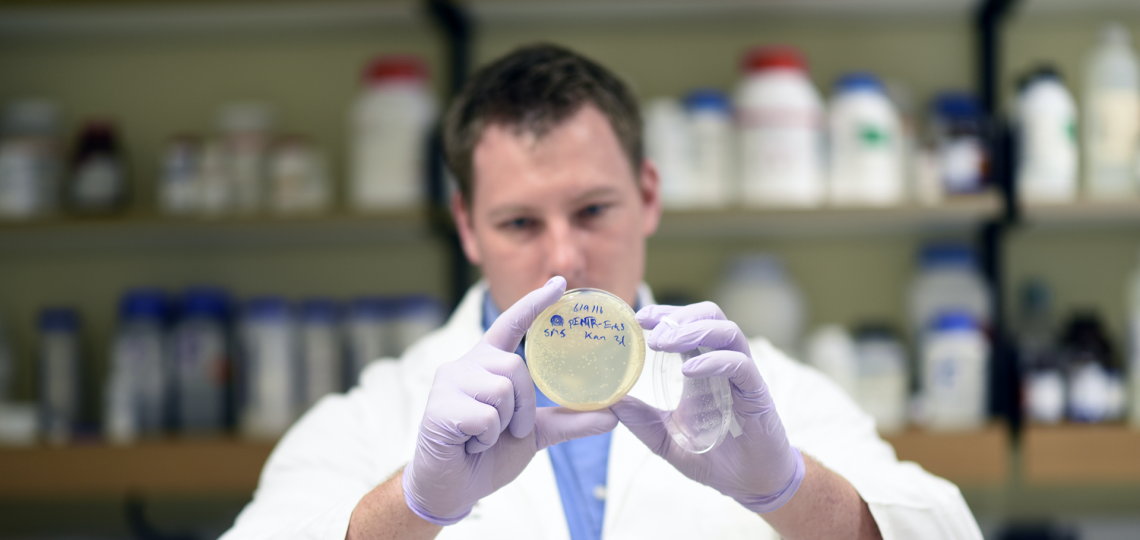
BCM OBGYN researcher in the lab

Maternal-Fetal Medicine Units (MFMU)
Ob/Gyn became a member of the National Institutes of Health/National Institute of Child Health and Human Development (NICHD) Maternal-Fetal Medicine Units (MFMU) Network, which is the premier multicenter clinical trials network for maternity-related studies.
The Department of Obstetrics and Gynecology at Baylor College of Medicine and Texas Children’s Hospital is dedicated to advancing health and well-being for all women and their infants. A key cornerstone of our ability to do so rests on our clinical and translational research.
Research Focus
Our research work is focused on the advancement the health of women (and, for women who are pregnant, their infants) through research and its translation into improved clinical practice. Within our programs we train the next generation of physicians, scientists, and clinical scientists in the ethical, impactful, and successful conduct of women’s health research.
Research Highlights
- We are internationally recognized for innovative, high-risk/high reward, ground breaking research in women’s reproductive health and fetal disease.
- We are a leader in the United States and international medical and scientific communities for the publication and recipient of funding for high-impact, translatable research focused on women’s reproductive health and fetal disease.
- We are an active member of the National Institutes of Health (NIH)/National Institute of Child Health and Human Development (NICHD) Maternal-Fetal Medicine Units (MFMU) Network, the premier multicenter clinical trials network for maternity-related studies.
- Our department leadership recognizes and cultivates research talent and potential among all our learners and faculty members. We translate that potential into their receipt of successful funding and publications, providing original and impactful work that benefits our community of patients and society.
Our Research Program
We have developed an active and holistic research program from “lab bench to bedside and back to lab bench” wherein scientists and clinicians are partnered and engaged in basic science, translational, and clinical research taking full advantage of the outstanding research infrastructure at Baylor College of Medicine and Texas Children’s Hospital
The areas of research are broad and encompass the following:
- Studies on the developmental origins of adult onset disorders, complications of pregnancy such as stillbirth, preterm labor and twin-two-twin transfusion syndrome, reproductive genetic disorders, developmental disorders, gynecologic malignancies, and endometriosis.
- Investigation of causes and treatments for everyday problems that women encounter, like heavy periods or bladder incontinence after vaginal birth.
- A state-of-the-science fetal surgery program, which has discovered new ways to treat congenital anomalies before babies are born, and prevent lifelong complications from occurring. We develop new and innovative ways to enable children and adolescents with vaginal stenosis to recover from corrective surgeries.
- Engagement in optimizing the care of teens seeking reproductive health testing and services across Houston.
- We follow children and grandchildren of women exposed to DES when they were pregnant in the 1960’s and 1970’s.
- We are leaders in environmental health research in pregnancy, and partner on issues of environmental justice.
- In just about every corner of women’s health and reproductive health you will find one of our faculty or learners engaged in the research that will lead to happier and healthier women in the future.

Research Education Activities
In addition to our CME-accredited activities, we also have non-CME-accredited research education activities. Presenters and attendees can expect to enhance their research through peer feedback, build collaborative networks and stay updated on emergent research in an interactive and engaging group forum.
Activity: OB/GYN Research Roundtable
Day/Time: Thursdays from September to May from 12 - 1 p.m., at the TCH Pavilion for Women II, 6620 Main St., 11th Floor Library, OB/GYN Faculty Conference Room H1160.22A/B. Please email the seminar coordinators to be added to the listserv to receive Outlook invitations.
Seminar Series Coordinators: Enrico R. Barrozo, Ph.D; Jessian L. Munoz, M.D., Ph.D.
Statement of Purpose: The OB/GYN Research Roundtable is designed to advance ongoing and future research within the department. It provides a platform for OB/GYN faculty, fellows, and trainees to present their basic and translational research, engage in productive discussions, and receive thoughtful feedback. These meetings also offer opportunities for team-building, knowledge sharing, and fostering collaboration within the department and the wider TMC community.
Presenters: OB/GYN faculty, fellows, residents, graduate students, postdocs, research staff, and trainees.
Target Audience: OB/GYN faculty, fellows, residents, graduate students, postdocs, research staff, and trainees. Baylor College of Medicine, Texas Children’s Hospital and Texas Medical Center community members are welcome to attend.
Laboratory Space
Investigators in the Department occupy over 12,000 square feet of laboratory space on the Baylor College of Medicine main research campus, Jan and Dan Duncan Neurological Research Institute and Feigin Center at Texas Children’s Hospital. You will find us in the clinics, labor and delivery wards, and operating rooms at Texas Children’s and Ben Taub Hospital, Baylor-St. Luke’s Hospital, the VA Medical Center, the Dan L. Duncan Cancer Center, the Baylor Teen Health Clinics, and just about everywhere you encounter women and adolescent females seeking our care.
To learn more about our faculty labs, please visit their pages:
Collaborations and Multi-Center Trials
We value collaborations with our colleagues near and far. We have active ongoing research collaborations with investigators from other departments and research centers at Baylor and Texas Children’s, including the Dan L Duncan Comprehensive Cancer Center, the Baylor College of Medicine Human Genome Sequencing Center, the Department of Pathology and Immunology, the Department of Molecular and Cellular Biology, and the Department of Molecular and Human Genetics.
Our investigators have played leading roles in major NIH studies throughout the last 20 years. Studies include multicenter trials such as the Human Microbiome Project, NIH/NICHD Maternal-Fetal Medicine Units (MFMU) clinical trials, women’s cancer trials, and other clinical trials that are changing OB/GYN care for all women.
Further research is also funded by the National Institutes of Health, the March of Dimes, the Burroughs-Wellcome Fund, the Preeclampsia Foundation, the National Cancer Institute, and various private foundations. Fellows and residents in the department pursue research projects with departmental faculty, culminating in national and local presentations. Our labs also host visiting Ph.D. graduate students and postdoctoral fellows.